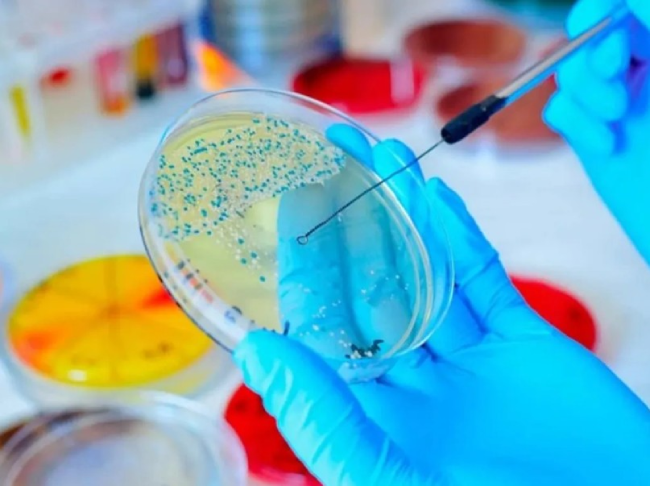
Screenshot 2025 05 28 165614

Três anos após sua fundação, a startup de biotecnologia ÄIO, sediada em Talin, capital da Estônia, lança seu primeiro produto: um óleo em pó rico em gordura, proteína e fibras, derivado de resíduos agroindustriais e leveduras oleaginosas.
Inovação estoniana com DNA brasileiro
A empresa foi criada pela biotecnóloga brasileira Nemailla Bonturi e pelo bioengenheiro estoniano Petri-Jaan Lahtvee, ambos pesquisadores da Universidade Tecnológica de Talin (TalTech).
A novidade já foi aprovada para uso cosmético pelas autoridades europeias. A próxima aposta da empresa é o RedOil, um óleo líquido com cor vibrante e aplicação no setor alimentício, que aguarda aprovação regulatória até o fim de 2025.
Microrganismos como alternativa aos óleos convencionais
Os chamados óleos microbianos (ou SCO – single cell oils) surgem como alternativas sustentáveis às gorduras animais e aos óleos vegetais, como o de palma, amplamente usado em alimentos industrializados e cosméticos. Se produzidos em larga escala, também podem ser utilizados na produção de biodiesel e combustíveis sustentáveis de aviação (SAF).
“Nós somos uma das empresas pioneiras no mundo nesse setor”, afirma Bonturi, que se mudou para a Estônia em 2016 após seu doutorado na Unicamp, motivada pelo cenário político instável no Brasil à época.
Leveduras e resíduos: matéria-prima sustentável
A ÄIO utiliza a levedura Rhodotorula toruloides, que pode conter mais de 20% de lipídios em sua massa seca. Esses microrganismos também produzem carotenoides, pigmentos com propriedades antioxidantes. Além da levedura, a empresa emprega resíduos como serragem – abundante na Estônia – como substrato para cultivo, valorizando o reaproveitamento e a economia circular.
A produção de óleo microbiano é mais rápida e menos impactante do que a de óleos vegetais, pois dispensa grandes áreas de cultivo, requer menos água e gera menos emissões de carbono. Em algumas horas, reatores já são capazes de gerar os lipídios desejados.

Pesquisa brasileira impulsiona o setor
O engenheiro químico Everson Miranda, da Unicamp, é um dos precursores no estudo de óleos microbianos no Brasil e coorientador de vários projetos com a equipe de Bonturi. Segundo ele, a produção de SCOs consome até 97% menos terra do que métodos convencionais e pode representar uma solução real para reduzir emissões globais de CO₂.
Estudos publicados mostram o potencial de aumentar a produção de lipídios em até 40% com estímulos como luz ou peróxido de hidrogênio durante o cultivo da levedura, otimizando a eficiência e o rendimento do processo.
Caminho até a escala industrial
Com 20 funcionários e mais de € 15 milhões arrecadados entre fundos de pesquisa e capital privado, a ÄIO conta com uma planta-piloto de 300 litros para testes. A produção comercial ainda é terceirizada, mas a empresa planeja inaugurar sua própria fábrica em dois a três anos, além de licenciar a tecnologia para outras companhias.
O desafio agora é escalar a produção sem comprometer a viabilidade econômica. O uso de microrganismos para transformar resíduos baratos em produtos de alto valor é visto por especialistas como uma estratégia chave para o futuro da indústria sustentável.

Óleo microbiano no combustível do amanhã
Pesquisadores do CNPEM, em Campinas, investigam o uso de óleos microbianos derivados do caldo de cana para produzir o SAF (Sustainable Aviation Fuel). A tecnologia, embora promissora, ainda enfrenta obstáculos como o custo elevado de produção, estimado entre US$ 1,83 e US$ 3 por litro – até quatro vezes o preço do querosene convencional.
Mesmo assim, os cientistas projetam que o rendimento do SAF por hectare pode ser quatro vezes maior que o obtido com soja. O próximo passo será o desenvolvimento de leveduras adaptadas à biodiversidade brasileira, para tornar o processo mais competitivo.
Reconhecimento internacional e futuro promissor
A ÄIO foi premiada na categoria de Alimentos no Baltic Sustainability Awards em 2024. No mesmo período, Bonturi foi homenageada com o prêmio Egresso Destaque pela Unicamp, coroando uma trajetória marcada por inovação, coragem e colaboração científica internacional.
“Desde criança, ela queria ser cientista”, relembra Miranda. E hoje, com uma empresa pioneira em biotecnologia sustentável, esse sonho se traduz em impacto global.
Fonte: Pesquisa FAPESP











Você precisa fazer login para comentar.